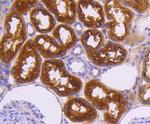
Neuropilin-1 Antibody in Immunohistochemistry (Paraffin) (IHC (P))

Search
Bioss
Neuropilin-1 Monoclonal Antibody (49H9)
{{$productOrderCtrl.translations['antibody.pdp.commerceCard.promotion.promotions']}}
{{$productOrderCtrl.translations['antibody.pdp.commerceCard.promotion.viewpromo']}}
{{$productOrderCtrl.translations['antibody.pdp.commerceCard.promotion.promocode']}}: {{promo.promoCode}} {{promo.promoTitle}} {{promo.promoDescription}}. {{$productOrderCtrl.translations['antibody.pdp.commerceCard.promotion.learnmore']}}
产品信息
BSM-52479R
宿主/亚型
分类
类型
克隆号
抗原
偶联物
形式
浓度
保存条件
运输条件
靶标信息
Neuropilin 1 is a 923 amino acid containing membrane bound coreceptor to a tyrosine kinase receptor belonging to the neuropilin family with two CUB domains, two F5/8 type C domains and a MAM domain. Neuropilin 1 forms a heterodimer with NRP2 (Neuropilin 2) and is known to bind to plexin (PLXNB1) to form semaphorin receptors. Expressed mostly in the nervous system this receptor is implicated in a wide range of functions including in the development of the cardiovascular system, angiogenesis, repulsive axon guidance, formation of certain neuronal circuits, cell survival, control of neuronal migration and organogenesis outside the nervous system. This semaphorin receptor functions as receptors for both the semaphorins and vascular endothelial growth factor and is also a regulator of VEGF-induced angiogenesis. Neuropilin 1 may be involved in aggressive advanced prostate carcinoma and in the progression of breast cancer.
仅用于科研。不用于诊断过程。未经明确授权不得转售。